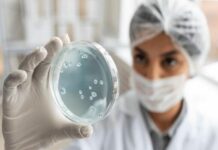

O projeto do túnel Santos-Guarujá, bem como os impactos da obra, serão tema de audiência pública a ser realizada na Câmara Municipal (Avenida Leomil, 291 – Pitangueiras) na próxima segunda-feira (19), às 18 horas. Será a primeira audiência pública sobre o tema, uma iniciativa da Comissão de Assuntos Relevantes instituída pelo Legislativo de Guarujá, presidida pelo vereador da cidade.
O evento vai discutir detalhes como saídas para aprimorar a mobilidade urbana na Cidade, com a possibilidade de instalação do Veículo Leve sobre Trilhos (VLT), os impactos nos bairros e comércio da região e a geração de emprego e renda com a qualificação de mão de obra da Cidade, resultando em mais empregos para os guarujaenses.
Além disso, após a apresentação do projeto por parte da Autoridade Portuária de Santos, haverá participação dos munícipes, que poderão formular perguntas. A participação popular é um requisito previsto no artigo 4º da Lei Complementar n.º101 de 04 de maio de 2000, e art. 165, § 2º, da Constituição Federal.
Túnel Santos-Guarujá
Com um orçamento de quase R$ 6 bilhões entre recursos federais e estaduais, o túnel Santos-Guarujá é a maior obra prevista no Programa de Aceleração de Crescimento (Novo PAC) do Governo Federal.
A estrutura terá 1,5 km de extensão (870 metros imersos) e conectará as duas cidades com três faixas em cada sentido, além de incluir ciclovia, passagem de pedestres e uma faixa adicional para o Veículo Leve sobre Trilhos (VLT). Isso vai reduzir o tempo de travessia, que hoje é de 20 minutos a duas horas, a menos de cinco minutos.